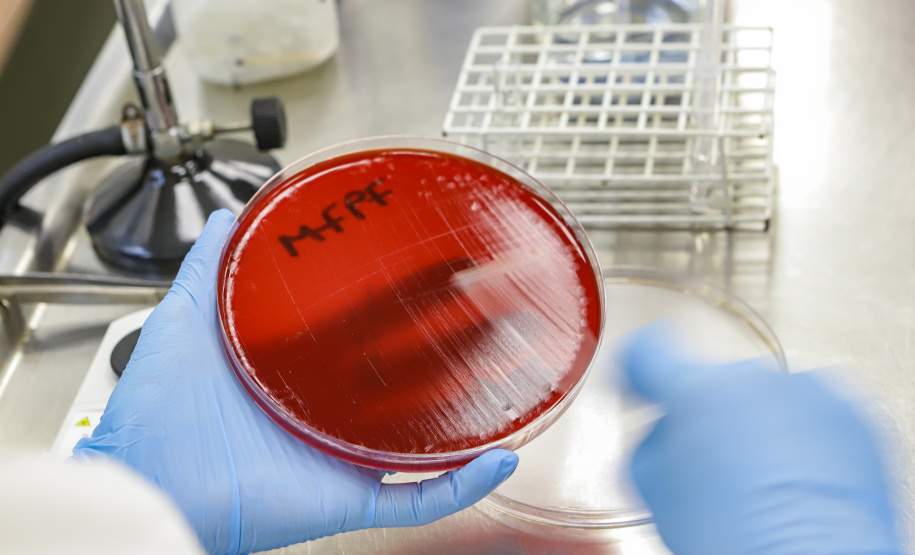
Lacen vira referência nacional e sai na vanguarda em projetos de monitoramento

O Laboratório Central do Estado (Lacen) é o laboratório de referência para a saúde pública no Paraná. Nele, são feitos exames voltados à vigilância epidemiológica e ao monitoramento de doenças infecciosas de notificação obrigatória. É ele quem gera os "alertas" que se transformam em políticas públicas de proteção das comunidades, campanhas de vacinação e reforço do atendimento em saúde em determinados locais, em parceria com as prefeituras. Nele foram detectados os primeiros casos de Covid-19 no Paraná, que ajudaram na formatação das primeiras medidas de distanciamento social em março de 2020, mas o trabalho é bem mais amplo, reconhecido nacionalmente, e envolve inovações no diagnóstico da raiva animal, monitoramento de resistência a antimicrobianos e controle da dengue.
Na quinta reportagem da série “Paraná, o Brasil que dá certo”, o Lacen, que completou 128 anos, tem ações que viraram referência no Brasil e projetos que influenciaram até o Ministério da Saúde. O DNA inovador da equipe técnica coloca o laboratório entre os melhores do País, com inovação constante nos processos e na infraestrutura localizada em São José dos Pinhais, na Região Metropolitana de Curitiba.
“Fazemos a detecção de doenças que podem afetar não somente o indivíduo que recebeu o diagnóstico, mas a saúde da população como um todo, o que requer ações imediatas do Poder Público. Os resultados e inovações produzidos no Lacen ajudam a formar um conceito muito importante e que envolve toda a sociedade, que é o que chamamos de Saúde Pública. Conseguimos mapear a circulação de doenças e contribuir com o bem-estar da população paranaense”, explica Celia Fagundes da Cruz, diretora do Lacen.
“O Lacen é um laboratório de excelência, pioneiro em novas tecnologias para realização de diagnósticos precisos que auxiliam na tomada de decisão”, complementa o secretário de Saúde, Beto Preto.
Um grande exemplo disso é o Programa Sentinela. Em parceria com a Secretaria de Estado da Saúde, o Lacen mantém 60 unidades sentinelas espalhadas pelo Estado. Cada uma envia, semanalmente, amostras coletadas de cinco pacientes ambulatoriais que tenham suspeita de dengue.
A análise dos resultados obtidos para essas amostras permite definir, de maneira regionalizada, quais são os sorotipos de dengue circulantes e se está ocorrendo introdução de dengue em regiões não endêmicas. Além disso, é possível também fazer o controle de outros arbovírus (Chikungunya, Zika e Febre Amarela).
À medida que o Lacen recebe as amostras das unidades, elas são tabuladas e verifica-se as tendências e eventual aumento do número de casos positivos, antes mesmo do problema se tornar maior. Assim, a Secretaria de Estado da Saúde consegue agir antes de eventuais surtos. Quando são detectados casos positivos, a vigilância epidemiológica faz o georreferenciamento dos casos, identificando focos e contendo a transmissão. Esse trabalho é feito de forma unificada pelo Estado, prefeituras e até mesmo a União. Desta forma, é possível agir de forma preventiva e rápida.
Guilherme Nardi Becker, farmacêutico do Lacen, explica que o projeto, além de otimizar recursos, permite que o Lacen faça a vigilância epidemiológica destes vírus e consiga detectar o aumento do número de casos de forma precoce. “Trata-se de um projeto pioneiro a trabalhar com unidades sentinelas para o diagnóstico de dengue”, afirma. “Nós tivemos, por exemplo, um caso de Chikungunya que foi apontado inicialmente como sendo de dengue e conseguimos detectar a diferença pela Unidade Sentinela. Desta forma, contivemos um surto antes dele se espalhar”.
O projeto, criado em 2020, também é uma excelente ferramenta para diminuir gastos. “Conseguimos dar as mesmas respostas epidemiológicas diminuindo em 50% o número de amostras processadas. Assim, é possível direcionar os recursos para aquilo que realmente precisamos aqui dentro do Lacen”, explica Becker. Outra novidade trazida pelo programa é a divulgação dos resultados do monitoramento das unidades em tempo real, pela internet. Assim, cada Regional de Saúde pode acessar o site do Lacen e acompanhar os indicadores.
A diretora técnica do Lacen, Irina Riediger, completa que, com esse tipo de abordagem, que auxiliou também no mapeamento da circulação de variantes do novo coronavírus nos últimos anos, é possível detectar precocemente a emergência de circulação ou a introdução de um novo sorotipo de dengue – ou de um outro arbovírus qualquer, como o SARS-CoV-2.
“Assim, conseguimos tomar as medidas de contenção ou de prevenção para a população de maneira precoce. Com isso conseguiremos, ao longo do tempo, reduzir a amplitude das epidemias, que é um foco de atenção desse século”, afirma.
RAIVA ANIMAL – Outro grande exemplo do trabalho inovador do Lacen é a mudança na forma de fazer o diagnóstico da raiva animal no Paraná. O laboratório, seguindo determinação da Organização Mundial da Saúde (OMS), foi o primeiro do País a deixar de usar testes em animais para a prova biológica da raiva. O método de pesquisa anterior consistia na verificação do vírus da raiva com a utilização de camundongos, prática que foi substituída pelo método in vitro, no qual se pesquisa o material genético do vírus diretamente do tecido do paciente.
“O teste em animais está tecnologicamente ultrapassado. A sociedade civil está se organizando de tal maneira a procurar reduzir ao mínimo o número de experimentos animais para a validação de qualquer produto ou serviço que façamos uso como sociedade. E o laboratório fez parte desse movimento, com pioneirismo”, afirma Irina.
Com a adoção da nova sistemática, além de deixar de usar animais vivos nos testes, o Lacen reduziu de 30 dias para uma semana o prazo para divulgação dos resultados deste tipo de exame. Com o uso dos animais vivos, isso não era possível porque havia dependência do desenvolvimento da doença induzida no animal explorado como cobaia. O trabalho do laboratório passou por validações, ajustes e depois de um ano foi publicado.
“Cedemos esse protocolo para os outros laboratórios brasileiros, que agora estão implantando a mesma sistemática. Cedemos também para o Ministério da Saúde, que está trabalhando na descentralização dessa técnica que nasceu aqui com a gente”, conta a diretora-técnica.
A raiva é uma doença infecciosa viral aguda, que acomete mamíferos, inclusive o homem, e caracteriza-se como uma encefalite progressiva e aguda com letalidade de aproximadamente 100%. É causada pelo vírus Lyssavirus. Ele é transmitida ao homem pela saliva de animais infectados, principalmente por meio da mordedura, podendo ser transmitida também pela arranhadura e/ou lambedura desses animais.
BACTÉRIAS – O Lacen também é referência nacional quando o assunto é o monitoramento de resistência a antimicrobianos. Em ambientes hospitalares, pacientes que ficam muito tempo internados acabam contraindo bactérias multirresistentes para as quais não existem drogas ou opções terapêuticas, e que acabam levando a óbito. O que o Lacen faz é monitorar a emergência dessas bactérias, como elas se comportam ao longo do tempo e como elas se distribuem no espaço.
“Isso ajuda quem trabalha nos hospitais a conhecer quais são as bactérias que estão naquele ambiente e como fazer um manejo melhor das drogas a serem implementadas dentro do rol de drogas disponíveis daquela instituição”, explica Irina.
De acordo com Marcelo Pillonetto, farmacêutico bacteriologista do Lacen, desde 2014 o laboratório é um dos quatro do País designados pela Anvisa para fazer este tipo de monitoramento. “Fazemos um serviço de vigilância de epidemiologia, no qual recebemos amostras de vários estados e detectamos qual mecanismo de resistência aquela bactéria possui. A partir disso, vemos a clonalidade, ou seja, qual é a semelhança da bactéria que está no hospital A, B ou C e aí podemos ver como elas estão circulando de um hospital para outro”, explica.
No ano passado, o Lacen venceu um edital da Coordenação Geral de Laboratórios de Saúde Pública do Ministério da Saúde e se tornou uma das 24 instituições no mundo a fazer este tipo de monitoramento. “No Brasil ficamos como referência e somos responsáveis por coordenar uma rede formada por 15 hospitais sentinelas espalhados por 11 estados brasileiros”, afirma Pillonetto.
"Nós capacitamos e treinamos estas equipes para detectar bactérias resistentes, testar e aprovar metodologias que identifiquem essas bactérias mais rapidamente. Nós também damos treinamentos para as equipes de microbiologistas para que eles melhorem o seu conhecimento e consigam fazer melhor esse serviço", complementa.
Para o segundo ano do projeto, a Anvisa também passou a integrar a ação e cuidará do controle e prevenção dessas doenças no ambiente hospitalar. “Esses hospitais estão em contato continuamente conosco, conversando sobre novas bactérias que surgem, que produzem novas variantes, até mesmo novos genes de resistência. Com os dados em mãos, condensamos, analisamos e damos feedback para o Ministério, para os laboratórios regionais, para os hospitais sentinelas e, assim, tentamos controlar melhor a disseminação dessas bactérias resistentes”, arremata.
SÉRIE – “Paraná, o Brasil que dá certo” é uma série de reportagens da Agência Estadual de Notícias. São apresentadas iniciativas da administração pública estadual que são referência para o Brasil em suas áreas. A primeira abordou o sistema estadual de transplante de órgãos, a segunda a companhia master de dança mais longeva do País, a terceira a cadeia de produção e distribuição de alimentos orgânicos e a quarta a sala exclusiva do Museu Oscar Niemeyer para atender o público autista.
Confira o vídeo: